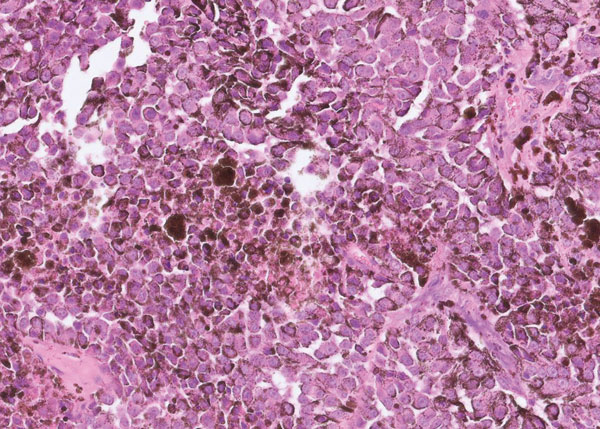

UCD Research - UCD 2022
’One Health’ Comparative Oncology Research
Comparative oncology is the discipline that integrates naturally occurring cancers seen in veterinary medicine, into more general studies of cancer biology and therapy in humans, including the study of cancer-pathogenesis and new treatments1. Several comparative oncology projects are currently ongoing in UCD
In association with


Dr Stephanie Bollard
MB BCh BAO MCh MRCSI,
PhD candidate, UCD

Jane Howard
BSc, PhD candidate,
UCD
Two ‘One Health’ comparative oncology projects involve a collaborative group of researchers from the School of Veterinary Medicine and the School of Medicine. This multidisciplinary group includes: Dr Pamela Kelly, Veterinary Pathologist; Professor Shirley Potter, Consultant Plastic and Reconstructive Surgeon at the Mater Misericordiae University Hospital; and Professor Amanda McCann, Principal Investigator and Senior Conway Fellow in the UCD Conway Institute of Biomolecular and Biomedical Research. Dr Stephanie Bollard and Jane Howard are PhD candidates in the group.
Figure 1: Histology of canine melanoma.
Comparative Oncology: melanoma
Dr Stephanie Bollard is a Specialist Registrar in Plastic and Reconstructive Surgery. Stephanie is an Irish Clinical Academic Training (ICAT) fellow currently undertaking a PhD in Comparative Oncology with a focus on melanoma. Melanoma, the most aggressive skin malignancy, is responsible for 80 per cent of skin cancer deaths, yet our molecular understanding of this disease is poor. Chemokines are small chemoattractant cytokines that regulate cell trafficking in the tumour microenvironment and have become of interest as potential therapeutic targets2. Naturally occurring canine melanoma is one of the most common and aggressive malignancies in dogs (Figure 1), which shows striking biological homologies with human melanoma, therefore representing a valuable, novel, spontaneous, translational animal comparative cohort.
Studying melanoma in both humans and dogs in parallel offers many advantages, as any findings will remain applicable to both species, and potential therapeutics are also more likely to apply to both. Our research in UCD centres around identifying the role of chemokines in melanoma progression in humans and dogs, and its association with other markers of aggression such as mitotic index and tumour grade, looking at retrospective histology slides. We hope to expand this research to examine the role of chemokines in circulation, recruiting dogs with melanoma to our study and analysing plasma.

Table 1: Isolation of extracellular vesicles from cats and humans.
Comparative Oncology: mammary adenocarcinoma
Jane Howard BSc, a graduate of Biomedical, Health and Life Sciences, UCD, is currently in the second stage of her PhD. Jane’s project is focused on triple negative breast cancer (TNBC) in women and mammary adenocarcinoma in cats and is funded by the UCD Advance PhD programme. Feline mammary adenocarcinoma (FMAs) is the third most common tumour in cats. Most FMAs are malignant and demonstrate highly aggressive metastatic behaviour. Surgery alone remains the treatment of choice for these patients in Ireland. To develop earlier diagnostic tests and effective treatments, and to improve patient outcomes, we must understand the biology underpinning FMA. Research has demonstrated that cats may represent a comparative model for investigation of mammary carcinogenesis, most notably, Triple Negative Breast Cancer (TNBC)1,3.
TNBC is a subtype of breast cancer that typically lacks the expression of the oestrogen receptor (ER), progesterone receptor (PR), and does not overexpress the human epidermal growth factor receptor 2 (HER2). Targeted treatments are therefore limited. Extracellular Vesicles (EVs) are nanoparticles found in all biological fluids4. They have recently gained traction as biomarkers of disease as they are easily accessible from ‘liquid biopsies’ such as urine or plasma. In the cancer setting, EVs are known to facilitate intercellular communication and promote metastatic activity. miRNAs are small non-coding RNAs that can act as oncogenes, tumour suppressors or metastatic regulators in cancer. miRNAs packaged inside EVs play an important role in promoting metastasis by facilitating cell communication. One Health studies aim to investigate whether miRNAs are associated with FMA and TNBC and whether they or other proteins may be detected and used as a cancer biomarker in EVs from plasma (Table 1, created with Bio-render). This study will pave the way for the identification of novel therapeutic targets for the treatment of feline mammary adenocarcinoma and triple negative breast cancer.
-
Howard J, Wyse C, Argyle D, Quinn C, Kelly P, McCann A. Exosomes as Biomarkers of Human and Feline Mammary Tumours; A Comparative Medicine Approach to Unravelling the Aggressiveness of TNBC. Biochimica et Biophysica Acta (BBA) - Reviews on Cancer. 2020;1874(2):188431.
-
Bollard SM, Casalou C, Goh CY, Tobin DJ, Kelly P, McCann A, et al. Circulating Melanoma-Derived Extracellular Vesicles: Impact on Melanoma Diagnosis, Progression Monitoring, and Treatment Response. Pharmaceuticals. 2020;13(12):475.
-
Sommerville L, Howard J, Evans S, Kelly P, McCann A. Comparative gene expression study highlights molecular similarities between triple negative breast cancer tumours and feline mammary carcinomas. Veterinary and Comparative Oncology. 2022;20(2):535-8.
-
Howard J, Wynne K, Moldenhauer E, Clarke P, Maguire C, Bollard S, et al. A comparative analysis of extracellular vesicles (EVs) from human and feline plasma. Scientific Reports. 2022;12(1):10851.
In association with


Dr Stephanie Bollard
MB BCh BAO MCh MRCSI,
PhD candidate, UCD

Jane Howard
BSc, PhD candidate,
UCD













